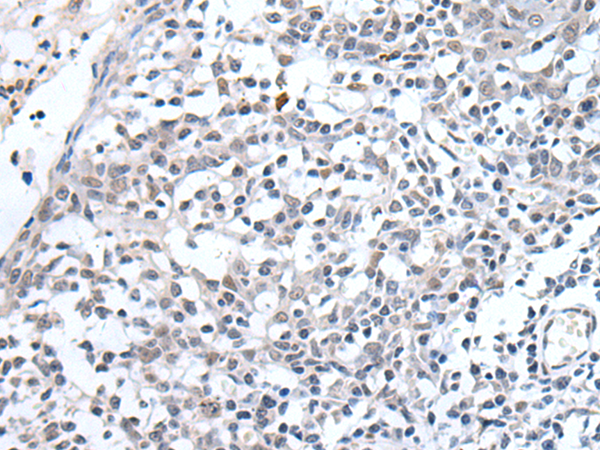

中文名稱: 兔抗ADAMTS7多克隆抗體
|
Background: |
The protein encoded by this gene is a member of the ADAMTS (a disintegrin and metalloproteinase with thrombospondin motifs) family. Members of this family share several distinct protein modules, including a propeptide region, a metalloproteinase domain, a disintegrin-like domain, and a thrombospondin type 1 (TS) motif. Individual members of this family differ in the number of C-terminal TS motifs, and some have unique C-terminal domains. The protein encoded by this gene contains two C-terminal TS motifs. |
|
Applications: |
ELISA, IHC |
|
Name of antibody: |
ADAMTS7 |
|
Immunogen: |
Synthetic peptide of human ADAMTS7 |
|
Full name: |
ADAM metallopeptidase with thrombospondin type 1 motif 7 |
|
Synonyms: |
ADAM-TS7; ADAMTS-7; ADAM-TS 7 |
|
SwissProt: |
Q9UKP4 |
|
ELISA Recommended dilution: |
2000-5000 |
|
IHC positive control: |
Human breast cancer and human tonsil |
|
IHC Recommend dilution: |
10-50 |

購物車
購物車 幫助
幫助
 021-54845833/15800441009
021-54845833/15800441009
